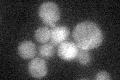
YNL257C
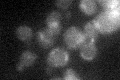
YNL257C
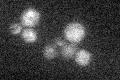
YNL257C

View description
Protein that activates transcription through interaction with DNA-bound Snf1p, C-terminal region has a putative leucine zipper motif; potential Cdc28p substrate
Localization:
Intensity:
Fold change:
Significance:
-
C’ GFP library in SD
cytosol20.54 -
N' NOP1pr-GFP in SD

ER43.6667 -
N' TEF2pr-mCherry in SD

ER21.8694 -
N' NATIVEpr-GFP in SD

ambiguous21.8185 -
N' TEF2pr-VC and Cyto-VN in SD

below threshold23.3801 -
C’ GFP library in SD+DTT

cytosol14.430.7No -
C’ GFP library in SD+H2O2
cytosol19.510.94No -
C’ GFP library in Starvation Media
cytosol17.690.86No -
C’ GFP library on the background of Pup2-DaMP

cytosol -
C’ GFP library on the background of CCT mutant

cytosol22.32651.08658No
